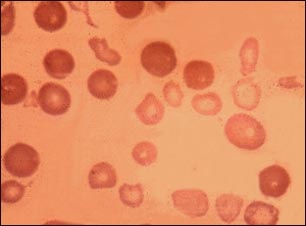
Talasemia mayor

![]() | ![]() | ![]() |
Talasemia mayor
La talasemia mayor es la forma más severa de anemia y es una forma hereditaria de la anemia hemolítica, caracterizada por anomalías en la producción de los glóbulos rojos sanguíneos (hemoglobina). La disminución del oxígeno en el organismo se manifiesta desde los 6 meses de edad y si no se le da tratamiento generalmente produce la muerte en unos pocos años. Aquí se pueden observar los glóbulos rojos sanguíneos de forma anormal, pálidos (hipocrómicos) y pequeños asociados con esta enfermedad. Las células más oscuras probablemente representan los glóbulos rojos normales de una transfusión de sangre.
Actualizado: 8/13/2008
